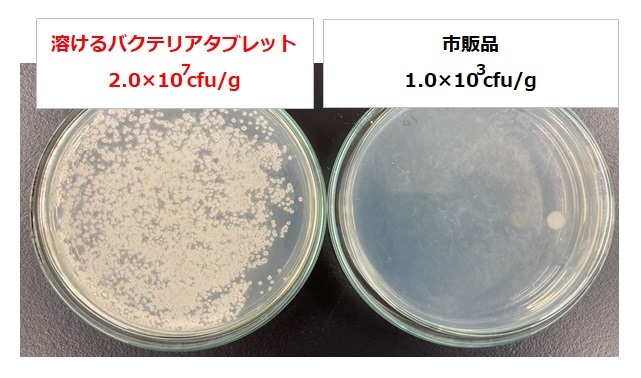

2021.02.25<br>
小型水槽にオススメのろ過バクテリアが出来ました
最近ではいろいろな形の水槽が登場し、様々な形のガラスの器(グラスアクアリウムなど)でお魚の飼育や水草、コケリウムなどを楽しむ方が増えています。
2020年は「おうち●●」という言葉が流行し、アクアリウム業界でも「おうちアクアリウム」という言葉が出る程でした。
小型のガラス容器でのお魚飼育では、水を綺麗にするフィルター・ろ過器が使えない、または使いづらいものもあるため、水質浄化という面ではまだまだ課題があります。 また、水を綺麗にしてくれるリキッドタイプのバクテリアも発売されていますが、どれくらい入れたらいいのか分からない、量るのが面倒・・というご意見を聞きます。
また、バクテリアをブロック状にしたものもありますが、レイアウトが気になって使いづらい、大きさが気になるという理由から使用をしていない方もいらっしゃると思います。
そんな方にオススメの商品「ベストバイオ 溶けるバクテリアタブレット」が発売になりました!
商品特徴
1箱で1億個のバクテリア
バチルス属バクテリアを、独自製法により生きたまま休眠状態でタブレット化。
入れるだけで有機物の汚れ(フンや残餌)を分解し水槽内をキレイに保ちます。
汚れ分解能力の実験
1.フラスコの中に滅菌水と観賞魚用フードを3粒ずつ入れます。
2.それぞれ「溶けるタブレット」1錠、液体のバクテリア5mLを使用した試験区と、何も入れないブランク(バクテリア剤未使用)の試験区を設定、シェーカーで振とうし、分解能力試験を行いました。

その結果、「溶けるバクテリアタブレット」を使用した試験区は餌が塊の形成を成しておらず、しっかり分解できていることが分かります。
菌数比較試験
滅菌水100mLに、「溶けるバクテリアタブレット」と同等の市販品をそれぞれ2.1gずつ溶かし、一般細菌用培地を用いて35℃環境で24時間培養しました。
その結果、本製品「溶けるタブレット」には十分な菌数が含まれていることが分かります。
消えて無くなる!?
水に溶けるので、レイアウトを気にせずご使用いただけます。
実際に溶かしてみました

その結果、1時間以内で溶けて無くなりました。
※環境により結果は異なる可能性がございます
ご使用方法
水槽設置時・水換え時に新しく入れる水10Lあたり1錠を入れてください。
フィルターまたはエアレーションを使用した水槽でお使いいただくと、バクテリアが活発になり効果的です。
使用量の目安は1か月に1回(~10Lに1錠)なので、分かりやすいですね。

フィルターを使用できない小型容器にも最適です。
また、フィルターの補助としても使用できます。
提供元:ジェックス株式会社

 わたしたちDIYer
わたしたちDIYer
